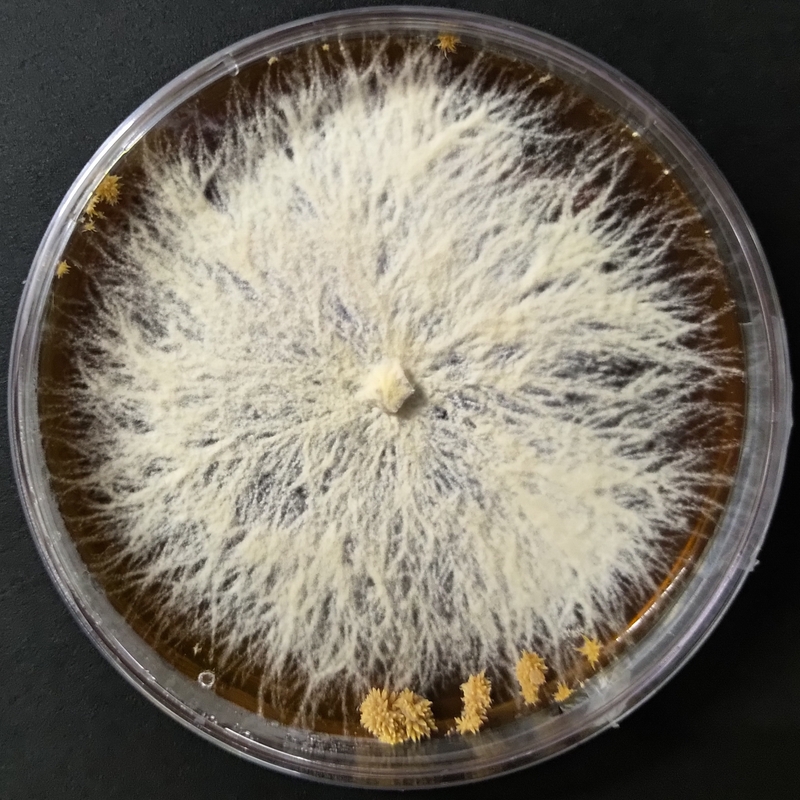
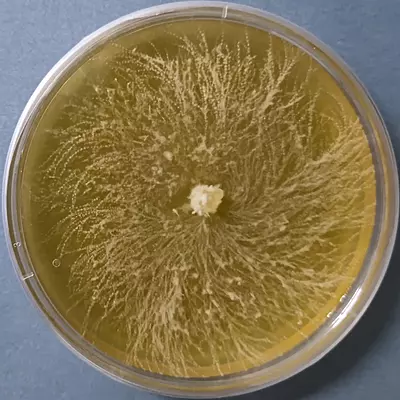

Heat Tolerant Lion’s Mane (Hericium erinaceus) – Pure Culture Plate
A superior heat-tolerant strain of Lion’s Mane (Hericium erinaceus) ideal for its cultivation at relatively higher temperature (20-25 deg C) than the normal strain (15-20 deg C) . This pure culture plate ensures vigorous mycelial growth and reliable fruiting even under higher temperatures, perfect for commercial and research cultivation.
This Heat Tolerant Lion’s Mane (Hericium erinaceus) – Pure Culture Plate fruits at relatively higher temperature. Known for its unique neural-supporting compounds and culinary excellence, this strain thrives where regular Lion’s Mane varieties struggle.
Ideal for commercial mushroom growers, labs, and researchers, this culture guarantees purity, strong colonization, and superior yields.
Features:
Heat-tolerant strain suitable for tropical and subtropical climates
Fast and dense mycelial growth
Excellent yield and fruit body formation
Authentic Hericium erinaceus species, verified pure culture
Perfect for both gourmet and medicinal mushroom production

|
| 
